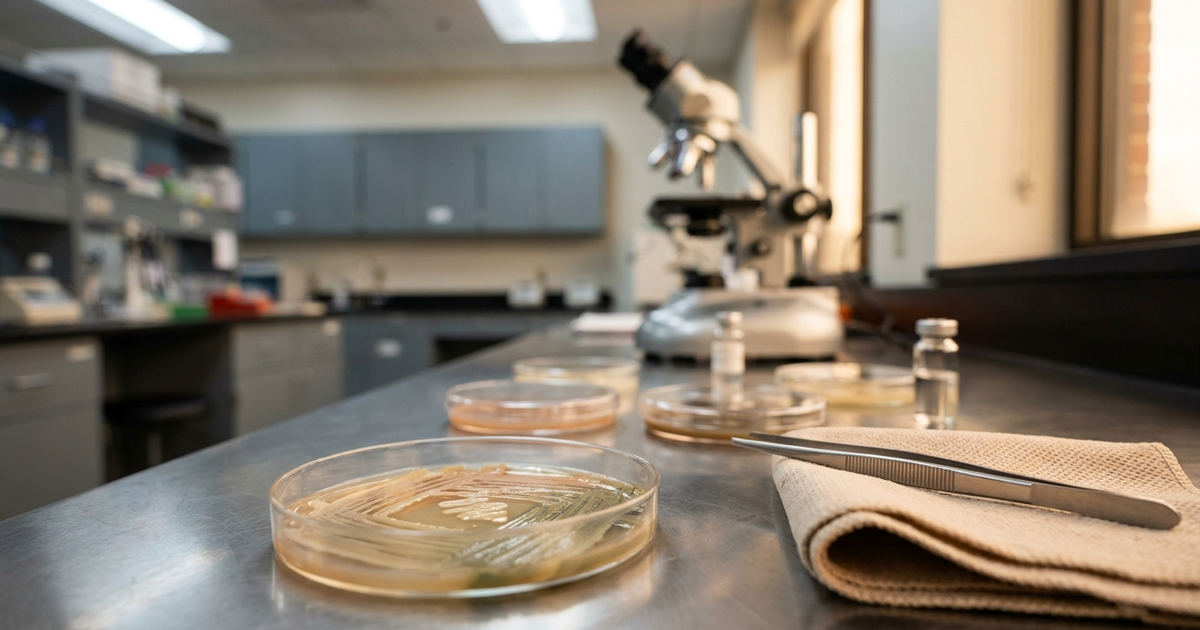

What's the Connection Between Gum Disease and IBD - Inflammatory Bowel Diseases?

This article is for informational purposes only and does not constitute medical advice. Always consult your healthcare provider before making any changes to your treatment plan.
Gum disease and inflammatory bowel disease (IBD) seem like they belong to different worlds - one in the dentist's chair, the other in the gastroenterologist's office. But research over the last decade has revealed that these two conditions are far more connected than anyone suspected, and understanding that link may reshape how we care for the whole body when we live with Crohn's or ulcerative colitis.
Key Takeaways
- People with Crohn's disease are up to three times more likely to develop gum disease than the general population, reflecting a real and measurable link (1)
- Severe gum disease is associated with roughly a 30% higher risk of developing Crohn's disease, suggesting the relationship runs in both directions (1)
- Chronic inflammation, microbiome imbalance, and immune dysregulation are the three mechanisms most likely to connect the two conditions
- Oral bacteria such as Porphyromonas gingivalis have been detected in the gut of IBD patients, hinting at a literal mouth-to-gut pathway (2)
- Good oral hygiene, regular dental visits, and an anti-inflammatory diet are practical steps that support both oral and gut health
- IBD patients should inform their dentists about medications and disease status, because some procedures require coordinated care
Objective of the Article
This article aims to explore the connection between gum disease and inflammatory bowel diseases (IBD), analyze the current literature on the topic, and highlight the potential underlying mechanisms linking these two inflammatory conditions. It discusses the possible bidirectional relationship between oral and gastrointestinal health and how understanding this connection can contribute to developing new therapeutic approaches for both gum disease and IBD.
The Complex Link: How Are Gum Disease and IBD Related?
Gum disease and IBD are linked through a bidirectional relationship in which each condition appears to raise the risk of the other. Large observational studies suggest that people with Crohn's disease are roughly three times more likely to have gum disease, and that severe periodontitis is associated with about a 30% higher risk of developing Crohn's (1). The mechanisms linking them include chronic inflammation, shared microbial pathways, and immune dysregulation.
Gum disease is a common oral condition, while IBD encompasses a group of chronic inflammatory disorders affecting the digestive system. However, recent evidence suggests that there may be a complex bidirectional link between these two conditions. While the exact mechanisms linking gum disease and IBD are not fully understood, it is believed that inflammation, the microbiome, and immune system dysregulation may be key factors driving this connection.
The exact nature of the connection between gum disease and IBD is complex and multifactorial. One proposed mechanism is that both conditions share a common pathway of chronic inflammation. Inflammation is a hallmark of both gum disease and IBD, and it is thought that inflammatory molecules released in the mouth may contribute to the development and progression of IBD. Conversely, inflammation in the gut may trigger the release of inflammatory mediators that can contribute to the development of gum disease.
Another potential link between gum disease and IBD is the microbiome. Both the oral and gut microbiomes play important roles in maintaining health and preventing disease. Disruptions in the microbiome have been implicated in the development of both gum disease and IBD. For example, periodontal pathogens such as Porphyromonas gingivalis have been identified in the stool of patients with IBD, suggesting that oral bacteria may play a role in the development of intestinal inflammation (2). Similarly, changes in the gut microbiome have been linked to the development of gum disease. As we discussed in our piece on the role of gut microbiome diversity in Crohn's disease, microbial balance plays a far greater role in IBD than was once appreciated.
Inflammation: A Common Mechanism?
Yes - chronic inflammation is arguably the single most important mechanism shared between gum disease and IBD. Both conditions involve immune-driven tissue damage fueled by pro-inflammatory cytokines, and anti-inflammatory strategies that work in one context (such as biologics) can sometimes have spillover benefits in the other.
Inflammation is a complex process involving the activation of immune cells and the release of various inflammatory mediators. In response to the accumulation of bacterial plaque, the body mounts an immune response that leads to the production of cytokines, chemokines, and other inflammatory molecules. These molecules contribute to the destruction of gum tissues and the development of gum disease.
Similarly, in IBD, chronic inflammation is driven by immune system dysregulation and the release of pro-inflammatory cytokines. Inflammatory cells infiltrate the intestinal lining and release a variety of cytokines, contributing to tissue damage and inflammation.
Although the exact mechanisms linking inflammation to disease are not fully understood, it is clear that inflammation plays a key role in the development and progression of both gum disease and IBD. Targeting inflammation may be an important strategy for preventing and treating these conditions. Anti-inflammatory medications, such as nonsteroidal anti-inflammatory drugs (NSAIDs) and biologics that target specific cytokines, have been used to treat IBD and may also have potential for treating gum disease.
The Microbiome: A Key Player in Both Gum Disease and IBD?
The microbiome is now thought to be one of the central stages on which both gum disease and IBD play out. Dysbiosis - a disrupted balance of microorganisms - is a feature of both conditions, and specific oral bacteria have been shown to translocate to the gut and drive intestinal inflammation in experimental models (2).
In gum disease, the accumulation of bacterial plaque triggers an immune response that leads to the destruction of gum tissues. The oral microbiome is thought to play an important role in the development of gum disease. Certain bacterial species, such as Porphyromonas gingivalis, have been implicated in the pathogenesis of gum disease. These bacteria produce virulence factors that contribute to tissue destruction and inflammation.
Similarly, in IBD, changes in the gut microbiome have been observed. Dysbiosis, or an imbalance in the composition of the microbiome, has been linked to the development of IBD. Studies have shown that patients with IBD have reduced microbial diversity and altered bacterial populations compared to healthy individuals. Furthermore, specific bacterial species, such as Escherichia coli and Fusobacterium nucleatum, have been implicated in the pathogenesis of IBD.
The relationship between the microbiome and disease is complex, and the exact mechanisms by which changes in the microbiome contribute to disease development are not fully understood. However, it is clear that the microbiome plays an important role in both gum disease and IBD. Modulating the microbiome may be a promising strategy for preventing and treating these conditions. Probiotics, prebiotics, and fecal microbiota transplantation (FMT) have been investigated as potential treatments for IBD and may also have implications for managing gum disease. Our piece on maintaining gut health with probiotics and prebiotics explores these tools in more practical detail.

Immune System Dysregulation: A Common Basis for Gum Disease and IBD?
Immune system dysregulation is the third leg of the stool that connects gum disease and IBD. In both conditions, the immune system responds to normal (or near-normal) microbial signals with an exaggerated inflammatory cascade that damages host tissue, and genetic predispositions to such dysregulation overlap significantly between the two.
Both gum disease and IBD are characterized by chronic inflammation, suggesting that immune system dysregulation may be a common underlying mechanism. In gum disease, the immune response to the accumulation of bacterial plaque leads to the destruction of gum tissues. In IBD, the immune response to dysbiosis and other environmental triggers results in chronic inflammation of the digestive system.
Both conditions are associated with changes in immune cell populations and the production of cytokines. Furthermore, a genetic predisposition to immune dysregulation has been implicated in the development of both gum disease and IBD.
"Healthy Mouth, Healthy Gut": The Importance of Oral Hygiene in Managing IBD
Good oral hygiene is one of the simplest and most overlooked tools for supporting IBD management. A healthy mouth keeps the oral microbiome in balance, reduces the burden of inflammatory bacteria that could travel downstream, and lowers the chronic low-grade inflammation that aggravates the whole system.
Studies have shown that maintaining good oral hygiene is important for managing IBD. A healthy mouth can contribute to a healthy gut, as the oral microbiome and gut microbiome are interconnected. Poor oral hygiene can lead to dysbiosis in the oral microbiome, which may contribute to dysbiosis in the gut microbiome. This dysbiosis can trigger inflammation and exacerbate IBD symptoms. Therefore, maintaining good oral hygiene is essential for reducing the risk of worsening IBD.
Regular dental check-ups and cleanings are important for preventing and treating gum disease, which is associated with an increased risk of developing and exacerbating IBD. Additionally, proper brushing and flossing can help prevent the accumulation of bacterial plaque, which can contribute to gum disease and systemic inflammation.
In addition to maintaining oral hygiene, adopting a healthy diet can also promote both gut and oral health. A diet rich in fiber and plant-based foods has been shown to promote a diverse gut microbiome and reduce inflammation. Similarly, consuming foods low in sugar and processed carbohydrates can help prevent dysbiosis in the oral microbiome. For a broader look at how food influences IBD, see our overview of nutrition and inflammatory bowel diseases.
Furthermore, some studies have shown that probiotics and prebiotics may be effective in managing IBD symptoms by modulating the gut microbiome. Similarly, probiotics may also play a role in maintaining a healthy oral microbiome. However, more research is needed to fully understand the effects of probiotics and prebiotics on both the gut and oral microbiomes.
Therapeutic Approaches: Can Targeting One Condition Improve the Other?
Emerging research suggests yes - treating gum disease may improve IBD outcomes and vice versa, because anti-inflammatory therapy in one system can reduce the overall inflammatory burden on the body. Antimicrobial agents, biologics, and microbiome-modulating strategies are all being explored as dual-purpose interventions (3).
One approach is the use of antimicrobial agents to reduce inflammation in both the oral and gut microbiomes. For example, the antibiotic metronidazole has been shown to improve both gum disease and IBD symptoms in some patients. However, the use of antibiotics can also lead to antibiotic resistance and dysbiosis in the gut microbiome, so their use must be carefully considered.
Another approach is the use of nonsteroidal anti-inflammatory drugs (NSAIDs) to target inflammation in both gum disease and IBD. Some studies have shown that NSAIDs can improve gum disease, and there is also evidence suggesting that NSAIDs may have a protective effect against the development of IBD. However, NSAIDs can also have negative effects, such as gastrointestinal bleeding, and their use must be carefully monitored.
Additionally, some studies have investigated the potential of targeting the gut microbiome to improve oral health outcomes. For example, probiotics have been shown to improve gum disease outcomes in some studies. However, more research is needed to fully understand the effects of probiotics on the oral microbiome and how they may impact IBD outcomes.
Future Perspectives: What Lies Ahead for Research on Gum Disease and IBD?
The next decade of research is likely to focus on pinpointing the specific bacterial species and immune pathways that connect gum disease to IBD, developing better biomarkers for both conditions, and moving toward personalized medicine. The goal is to stop treating these as separate problems and start treating them as two faces of the same inflammatory process.
In the future, more research is needed on the complex relationship between gum disease and IBD to better understand the underlying mechanisms. This research should focus on identifying the specific bacteria and immune pathways involved in the development of both gum disease and IBD. This could lead to the development of more targeted therapeutic approaches that address the underlying causes of both conditions.
Another area of future research is the development of biomarkers for gum disease and IBD. Currently, there are no reliable biomarkers for gum disease, making diagnosis and treatment challenging. Furthermore, while there are biomarkers for IBD, they are not always accurate, and more specific and sensitive biomarkers are needed to aid in diagnosis and treatment monitoring. Emerging non-invasive options like tracking IBD with sweat point toward a future of more accessible biomarkers.
Finally, future research should focus on the development of personalized medicine approaches for both gum disease and IBD. Given the complex interplay between the oral and gut microbiomes, as well as the heterogeneity of these conditions, a one-size-fits-all approach is unlikely to be effective. Instead, personalized approaches that take into account an individual's unique microbiome, immune system, and genetic profile may lead to more effective and targeted treatments for both gum disease and IBD.
The Importance of Dental Visits
Regular dental visits are particularly important for people with IBD, because both the disease and its medications can increase the risk of oral complications - and preventive care is far easier than reactive care. Ideally, IBD patients should see a dentist at least twice a year, with closer follow-up around surgeries or changes in immunosuppressive therapy.
Skipping dental visits is common among adults, especially when there are many other factors to consider. People with IBD already see various doctors regularly and may face significant financial burdens. As a result, routine dental cleanings and addressing other oral health issues may fall lower on the priority list.
However, as with many aspects of healthcare, proper preventive care is crucial to avoiding future problems. Brushing and flossing twice a day are recommended for most adults, but people with IBD should ask their dentists if additional daily care is necessary.
Finding a dentist with experience treating patients with IBD can take time. It may be helpful to ask a gastroenterologist for a recommendation for a local dentist experienced with IBD or other chronic conditions.
Certain dental procedures may require the use of antibiotics or NSAIDs, and it is essential to be monitored by a gastroenterologist when using these medications. Both antibiotics and NSAIDs have been shown to cause issues for some people with IBD, such as diarrhea or even flare-ups.
Increasingly, it is understood that IBD affects the whole person, including the mouth and teeth, although these may not be the focus for most people with IBD. It is worth discussing with a gastroenterologist about finding a dentist who can help not only with problems but also with preventive care. People with IBD may need to schedule additional cleanings or have a special oral care routine, especially before or after surgery. Informing the dentist about IBD and any medications is also crucial, especially when dental procedures are needed.
Conclusion
There is growing evidence suggesting a connection between gum disease and IBD, potentially due to shared inflammatory pathways, changes in the microbiome, and immune system dysregulation. More research is needed to fully understand the extent of this connection and its clinical implications. A comprehensive approach targeting both oral and gastrointestinal health may ultimately lead to improved treatment and outcomes for patients.
Frequently Asked Questions
Does having Crohn's disease mean I will definitely get gum disease?
No - increased risk does not mean certainty. People with Crohn's disease are roughly three times more likely to develop gum disease compared to the general population (1), but many patients with excellent oral hygiene and good disease control never experience significant periodontal problems. The risk is elevated, but it is also strongly modifiable through preventive care.
Can treating my gum disease help my IBD symptoms?
Possibly, though the evidence is still emerging. Some small studies suggest that reducing chronic inflammation in the mouth can lower systemic inflammatory markers and may have positive effects on gut inflammation (3). Even if the direct benefit on IBD is modest, treating gum disease prevents tooth loss and removes one source of inflammatory burden, which is valuable on its own.
Is it safe to have dental work done during an IBD flare?
Non-urgent dental work is generally better postponed until a flare settles, because stress, antibiotics, or NSAIDs used during dental procedures can sometimes aggravate IBD. Urgent dental issues such as abscesses should still be treated promptly, but always in coordination with your gastroenterologist so medications can be chosen carefully.
Do IBD medications affect my teeth and gums?
Yes, some can. Corticosteroids may increase the risk of oral infections and delay healing, while certain immunosuppressants can raise the risk of gum overgrowth or oral thrush. Biologics can increase susceptibility to infection in general, including oral infections. Always tell your dentist which medications you are taking so they can adjust their approach.
Should I use a special mouthwash or toothpaste if I have IBD?
No universal rule exists. Most IBD patients do well with a standard fluoride toothpaste and gentle brushing, though those with dry mouth (a common side effect of many medications) may benefit from alcohol-free mouthwashes and products designed for dry mouth. Your dentist can tailor recommendations to your specific needs.
How often should I see the dentist if I have Crohn's or ulcerative colitis?
At least twice a year is a reasonable baseline, and more often if you have active gum disease, are on high-dose immunosuppressants, or are preparing for major surgery. Ask your gastroenterologist whether your specific medications warrant a closer dental follow-up schedule.
Can probiotics help both my gum disease and my IBD?
There is early evidence that specific probiotic strains may benefit both oral and gut health, but the research is far from settled. Probiotics are not a substitute for proven IBD therapy, and the "right" strain for gum disease may not be the same as for IBD. Think of them as a potential adjunct rather than a standalone treatment.
References
- Lin C-Y, Tseng K-S, Liu J-M, et al. Association Between Periodontal Disease and Subsequent Inflammatory Bowel Disease: A Nationwide Population-Based Cohort Study. International Journal of Environmental Research and Public Health, 2018. Read study
- Kitamoto S, Nagao-Kitamoto H, Jiao Y, et al. The Intermucosal Connection between the Mouth and Gut in Commensal Pathobiont-Driven Colitis. Cell, 2020. Read study
- Crohn's & Colitis Foundation. Oral Health and IBD. Patient resource, accessed 2024. Read article
Recommended Resources
Browse ResourcesRelated Articles

Capsule Endoscopy for Crohn's Disease: A Patient Guide
Capsule endoscopy for Crohn's disease uses a tiny swallowable camera to image the entire small bowel. Learn how PillCam works, what to expect, and the risks.

MR Enterography for Crohn's Disease: A Patient's Guide
MR enterography for Crohn's disease is a radiation-free scan that maps small bowel inflammation. Learn how MRE works, what to expect, and why it matters.

Top-Down vs Step-Up Therapy for Crohn's: PROFILE Trial
PROFILE trial shows top-down therapy for Crohn's disease beats step-up: 79% sustained remission vs 15% at one year. What newly diagnosed patients need to know.

Subcutaneous Infliximab (Zymfentra) for Crohn's Disease
Subcutaneous infliximab (Zymfentra) is the first FDA-approved self-injection biologic for Crohn's disease. Learn how it works, who it fits, trial data.

Therapeutic Drug Monitoring for Crohn's: A Patient Guide
Therapeutic drug monitoring helps Crohn's disease patients on biologics like infliximab and adalimumab stay in remission. Learn how and when TDM is used.

Fecal Calprotectin Test for Crohn's Disease: Full Guide
Learn what your fecal calprotectin number means in Crohn's disease, with 2025 ACG and AGA cutoff guidelines and tips for tracking flares without scopes.